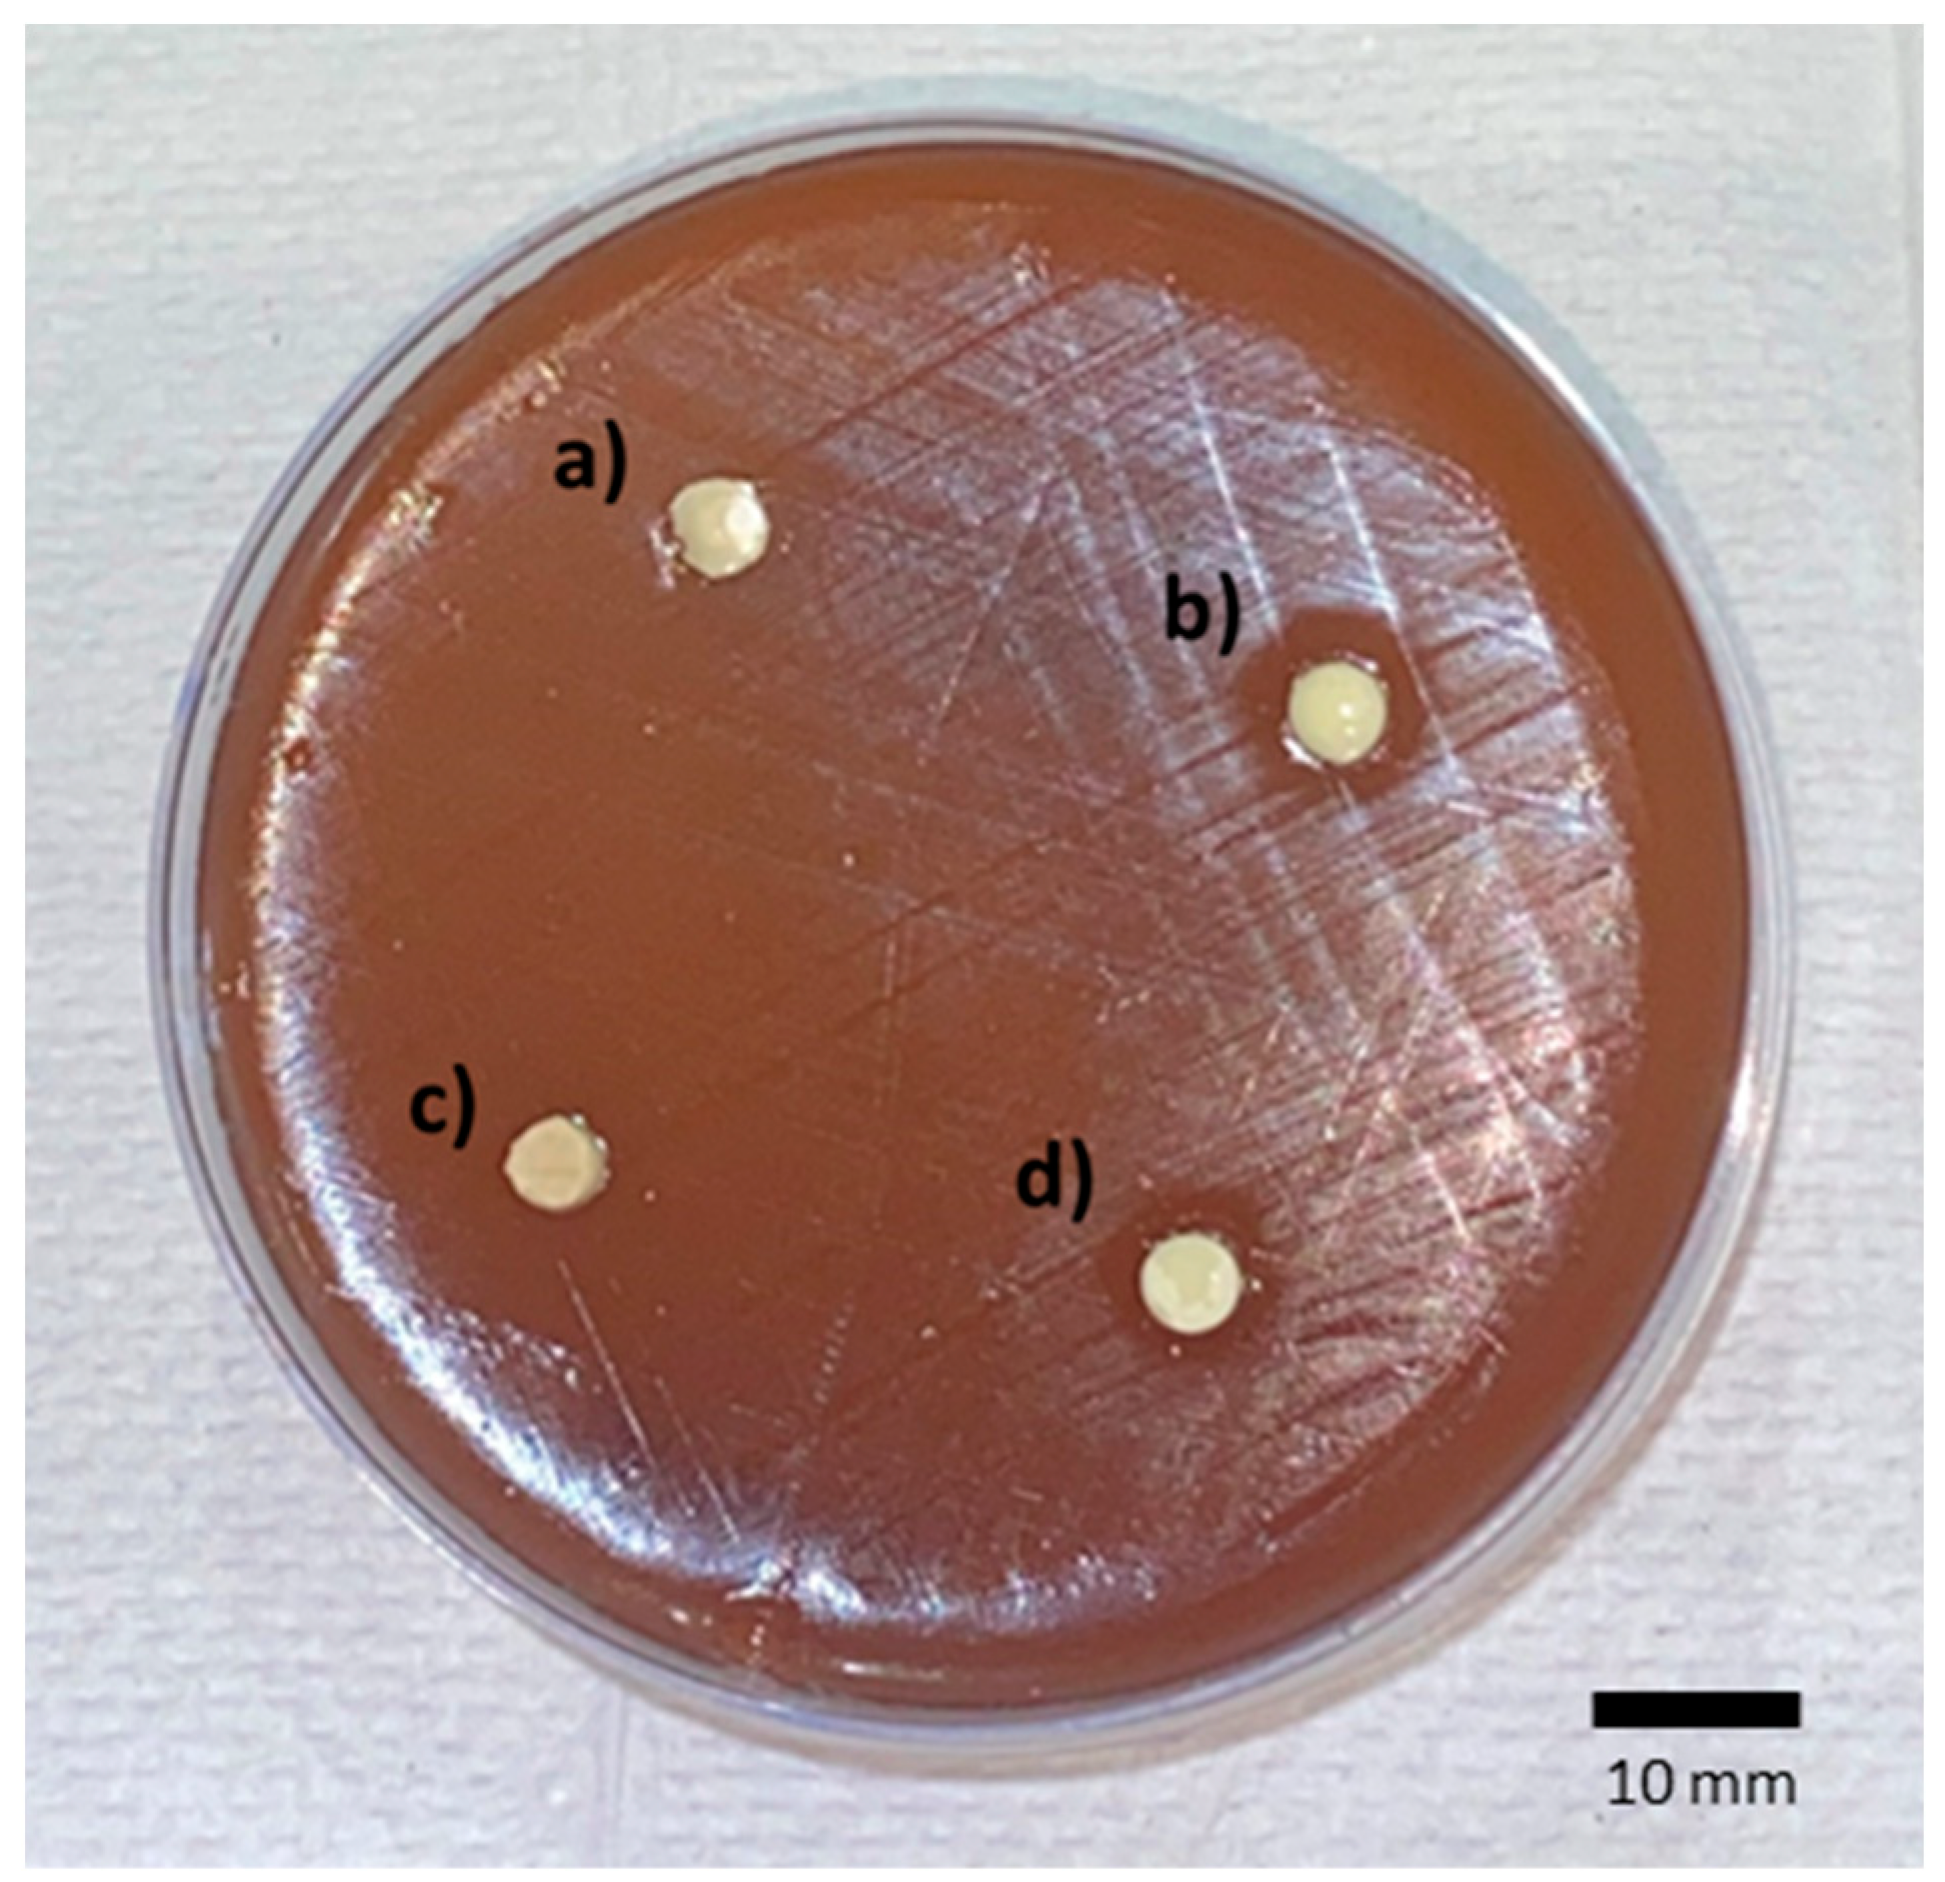
Inorganics 13 00190 g004

The Growth-Inhibitory Effect of Glass Ionomer Liners Reinforced with Fluoride-Modified Nanotubes
Abstract
1. Introduction
2. Results
3. Discussion
4. Materials and Methods
4.1. Determination of the Inhibitory Effect of Sodium Fluoride (NaF)
4.2. Inccorporation of Sodium Fluoride into Halloysite Nanotubes
4.3. Characterization of the Samples Using FTIR (Fourier Transform Infrared Spectroscopy)
4.4. Modification of Glass Ionomers with Preloaded Fluoride Halloysite Nanotubes
4.5. Microbiological Assay
4.6. Statistical Analysis
5. Conclusions
Limitations of the Study
Author Contributions
Funding
Institutional Review Board Statement
Informed Consent Statement
Data Availability Statement
Acknowledgments
Conflicts of Interest
References
- Soubhagya, M.; Goud, K.M.; Deepak, B.S.; Thakur, S.; Nandini, T.N.; Arun, J. Comparative in Vitro Evaluation of Internal Adaptation of Resin-Modified Glass Ionomer, Flowable Composite and Bonding Agent Applied as a Liner under Composite Restoration: A Scanning Electron Microscope Study. J. Int. Oral Health 2015, 7, 27–31. [Google Scholar] [PubMed]
- Weiner, R. Liners and Bases in General Dentistry. Aust. Dent. J. 2011, 56, 11–22. [Google Scholar] [CrossRef] [PubMed]
- Strober, B.; Veitz-Keenan, A.; Barna, J.A.; Matthews, A.G.; Vena, D.; Craig, R.G.; Curro, F.A.; Thompson, V.P. Effectiveness of a Resin-Modified Glass Ionomer Liner in Reducing Hypersensitivity in Posterior Restorations: A Study from the Practitioners Engaged in Applied Research and Learning Network. J. Am. Dent. Assoc. 2013, 144, 886–897. [Google Scholar] [CrossRef] [PubMed]
- Mitra, S.B. Adhesion to Dentin and Physical Properties of a Light-Cured Glass-Ionomer Liner/Base. J. Dent. Res. 1991, 70, 72–74. [Google Scholar] [CrossRef]
- Azevedo, L.M.; Casas-Apayco, L.C.; Villavicencio Espinoza, C.A.; Wang, L.; Navarro, M.F.D.L.; Atta, M.T. Effect of Resin-Modified Glass-Ionomer Cement Lining and Composite Layering Technique on the Adhesive Interface of Lateral Wall. J. Appl. Oral Sci. 2015, 23, 315–320. [Google Scholar] [CrossRef]
- Rodrigues, M.d.P.; da Cunha, L.S.; Vilela, A.B.F.; Schettini, A.C.T.; de Bragança, G.F.; França, R.; Soares, C.J. Selective Carious Tissue Removal and Glass Ionomer Liner Reduction of Pulp Stress in Bulk Fill Resin Composite Restorations. Braz. Oral Res. 2021, 35, e119. [Google Scholar] [CrossRef]
- Kasraei, S.; Azarsina, M.; Majidi, S. In Vitro Comparison of Microleakage of Posterior Resin Composites with and without Liner Using Two-Step Etch-and-Rinse and Self-Etch Dentin Adhesive Systems. Oper. Dent. 2011, 36, 213–221. [Google Scholar] [CrossRef]
- Güray Efes, B.; Yaman, B.C.; Gümüştaş, B.; Tiryaki, M. The Effects of Glass Ionomer and Flowable Composite Liners on the Fracture Resistance of Open-Sandwich Class II Restorations. Dent. Mater. J. 2013, 32, 877–882. [Google Scholar] [CrossRef]
- Caneppele, T.; Bresciani, E.; da Silva Ávila, D.; Barcellos, D.; Pucci, C. Effect of Lining Materials on Shear Bond Strength for Composite Restorations In Vitro. Int. J. Periodontics Restor. Dent. 2017, 37, 137–143. [Google Scholar] [CrossRef]
- Ranjbar Omrani, L.; Moradi, Z.; Abbasi, M.; Kharazifard, M.J.; Tabatabaei, S.N. Evaluation of Compressive Strength of Several Pulp Capping Materials. J. Dent. 2021, 22, 41–47. [Google Scholar] [CrossRef]
- Alsunbul, H.; Khan, A.A.; Alqahtani, Y.M.; Hassan, S.A.b.; Asiri, W.; Saadaldin, S.; Alharthi, R.; Aldegheishem, A. Using Functionalized Micron-Sized Glass Fibres for the Synergistic Effect of Glass Ionomer on Luting Material. J. Funct. Biomater. 2023, 14, 550. [Google Scholar] [CrossRef]
- Alsunbul, H.; Khan, A.A.; De Vera, M.A.T.; Bautista, L.S.J.; Javed, R. Utilizing an Oxidized Biopolymer to Enhance the Bonding of Glass Ionomer Luting Cement Particles for Improved Physical and Mechanical Properties. Biomimetics 2023, 8, 347. [Google Scholar] [CrossRef]
- De Magalhães, C.S.; Hara, A.T.; Turssi, C.P.; Serra, M.C.; Giannini, M. Microhardness Evaluation around Composite Restorations Using Fluoride-Containing Adhesive Systems. J. Appl. Oral Sci. 2005, 13, 259–264. [Google Scholar] [CrossRef]
- Duque, C.; Negrini, T.D.C.; Sacono, N.T.; Spolidorio, D.M.P.; De Souza Costa, C.A.; Hebling, J. Clinical and Microbiological Performance of Resin-Modified Glass-Ionomer Liners after Incomplete Dentine Caries Removal. Clin. Oral Investig. 2009, 13, 465–471. [Google Scholar] [CrossRef]
- Deepa, V.L.; Dhamaraju, B.; Bollu, I.P.; Balaji, T.S. Shear Bond Strength Evaluation of Resin Composite Bonded to Three Different Liners: TheraCal LC, Biodentine, and Resin-Modified Glass Ionomer Cement Using Universal Adhesive: An in Vitro Study. J. Conserv. Dent. 2016, 19, 166–170. [Google Scholar] [CrossRef]
- Askar, H.; Krois, J.; Göstemeyer, G.; Schwendicke, F. Secondary Caries Risk of Different Adhesive Strategies and Restorative Materials in Permanent Teeth: Systematic Review and Network Meta-Analysis. J. Dent. 2021, 104, 103541. [Google Scholar] [CrossRef]
- Torres, C.R.G.; Mailart, M.C.; Rocha, R.S.; Sellan, P.L.B.; Contreras, S.C.M.; Di Nicoló, R.; Borges, A.B. The Influence of a Liner on Deep Bulk-Fill Restorations: Randomized Clinical Trial. J. Dent. 2020, 102, 103454. [Google Scholar] [CrossRef]
- Yon, M.J.Y.; Gao, S.S.; Chen, K.J.; Duangthip, D.; Lo, E.C.M.; Chu, C.H. Medical Model in Caries Management. Dent. J. 2019, 7, 37. [Google Scholar] [CrossRef]
- ten Cate, J.M. Current Concepts on the Theories of the Mechanism of Action of Fluoride. Acta Odontol. Scand. 1999, 57, 325–329. [Google Scholar] [CrossRef]
- Naik, S.V.; Attiguppe, P.; Malik, N.; Ballal, S. CPP–ACP and Fluoride: A Synergism to Combat Caries. Int. J. Clin. Pediatr. Dent. 2019, 12, 120–125. [Google Scholar] [CrossRef]
- Lemos, J.A.; Palmer, S.R.; Zeng, L.; Wen, Z.T.; Kajfasz, J.K.; Freires, I.A.; Abranches, J.; Brady, L.J. The Biology of Streptococcus Mutans. Microbiol. Spectr. 2019, 7, 7. [Google Scholar] [CrossRef]
- Kovacs, C.J.; Faustoferri, R.C.; Bischer, A.P.; Quivey, R.G. Streptococcus Mutans Requires Mature Rhamnose-Glucose Polysaccharides for Proper Pathophysiology, Morphogenesis and Cellular Division. Mol. Microbiol. 2019, 112, 944–959. [Google Scholar] [CrossRef]
- Kucukyilmaz, E.; Savas, S.; Kavrik, F.; Yasa, B.; Botsali, M. Fluoride Release/Recharging Ability and Bond Strength of Glass Ionomer Cements to Sound and Caries-Affected Dentin. Niger. J. Clin. Pract. 2017, 20, 226–234. [Google Scholar] [CrossRef]
- Hironaka, N.G.L.; Trizzi, J.Q.; Yoshida, N.M.; Cury, J.A.; Tabchoury, C.P.M.; Botelho, J.N.; Pini, N.I.P.; Pascotto, R.C. Use of Sonic Waves in Bubble Formation, Microhardness and Fluoride Release of a High-Viscosity Glass-Ionomer Cement. J. Investig. Clin. Dent. 2019, 10, e12456. [Google Scholar] [CrossRef]
- Bamoussa, A.; Assery, M.; Pani, S. Fluoride Release and Recharge Abilities of Zinc-Reinforced Glass Ionomer Cement in Comparison to Traditional High Strength Glass Ionomers. Saudi J. Oral Sci. 2015, 2, 69. [Google Scholar] [CrossRef]
- Cibim, D.D.; Saito, M.T.; Giovani, P.A.; Borges, A.F.S.; Pecorari, V.G.A.; Gomes, O.P.; Lisboa-Filho, P.N.; Nociti-Junior, F.H.; Puppin-Rontani, R.M.; Kantovitz, K.R. Novel Nanotechnology of TiO2 Improves Physical-Chemical and Biological Properties of Glass Ionomer Cement. Int. J. Biomater. 2017, 2017, 7123919. [Google Scholar] [CrossRef]
- Morales-Valenzuela, A.A.; Scougall-Vilchis, R.J.; Lara-Carrillo, E.; Garcia-Contreras, R.; Salmeron-Valdes, E.N.; Aguillón-Sol, L. Comparison of Fluoride Release in Conventional Glass-Ionomer Cements with a New Mechanical Mixing Cement. Oral Health Prev. Dent. 2020, 18, 319–324. [Google Scholar] [CrossRef]
- Pradiptama, Y.; Purwanta, M.; Notopuro, H. Antibacterial Effects of Fluoride in Streptococcus Mutans Growth in Vitro. Biomol. Health Sci. J. 2019, 2, 1. [Google Scholar] [CrossRef]
- Najeeb, S.; Khurshid, Z.; Zafar, M.; Khan, A.; Zohaib, S.; Martí, J.; Sauro, S.; Matinlinna, J.; Rehman, I. Modifications in Glass Ionomer Cements: Nano-Sized Fillers and Bioactive Nanoceramics. Int. J. Mol. Sci. 2016, 17, 1134. [Google Scholar] [CrossRef]
- Ching, H.S.; Luddin, N.; Kannan, T.P.; Ab Rahman, I.; Abdul Ghani, N.R.N. Modification of Glass Ionomer Cements on Their Physical-Mechanical and Antimicrobial Properties. J. Esthet. Restor. Dent. 2018, 30, 557–571. [Google Scholar] [CrossRef] [PubMed]
- Kheur, M.; Kantharia, N.; Iakha, T.; Kheur, S.; Husain, N.A.H.; Özcan, M. Evaluation of Mechanical and Adhesion Properties of Glass Ionomer Cement Incorporating Nano-Sized Hydroxyapatite Particles. Odontology 2020, 108, 66–73. [Google Scholar] [CrossRef] [PubMed]
- Noori, A.J.; Kareem, F.A. Setting Time, Mechanical and Adhesive Properties of Magnesium Oxide Nanoparticles Modified Glass-Ionomer Cement. J. Mater. Res. Technol. 2020, 9, 1809–1818. [Google Scholar] [CrossRef]
- Malekhoseini, Z.; Rezvani, M.B.; Niakan, M.; Atai, M.; Bassir, M.M.; Alizade, H.S.; Siabani, S. Effect of Zinc Oxide Nanoparticles on Physical and Antimicrobial Properties of Resin-Modified Glass Ionomer Cement. Dent. Res. J. 2021, 18, 73. [Google Scholar] [CrossRef]
- Noori, A.J.; Kareem, F.A. The Effect of Magnesium Oxide Nanoparticles on the Antibacterial and Antibiofilm Properties of Glass-Ionomer Cement. Heliyon 2019, 5, e02568. [Google Scholar] [CrossRef]
- Chen, J.; Zhao, Q.; Peng, J.; Yang, X.; Yu, D.; Zhao, W. Antibacterial and Mechanical Properties of Reduced Graphene-Silver Nanoparticle Nanocomposite Modified Glass Ionomer Cements. J. Dent. 2020, 96, 103332. [Google Scholar] [CrossRef]
- Barman, M.; Mahmood, S.; Augustine, R.; Hasan, A.; Thomas, S.; Ghosal, K. Natural Halloysite Nanotubes/Chitosan Based Bio-Nanocomposite for Delivering Norfloxacin, an Anti-Microbial Agent in Sustained Release Manner. Int. J. Biol. Macromol. 2020, 162, 1849–1861. [Google Scholar] [CrossRef]
- Ostadhossein, F.; Moitra, P.; Altun, E.; Dutta, D.; Sar, D.; Tripathi, I.; Hsiao, S.-H.; Kravchuk, V.; Nie, S.; Pan, D. Function-Adaptive Clustered Nanoparticles Reverse Streptococcus Mutans Dental Biofilm and Maintain Microbiota Balance. Commun. Biol. 2021, 4, 846. [Google Scholar] [CrossRef]
- Fakhruddin, K.; Hassan, R.; Khan, M.U.A.; Allisha, S.N.; Razak, S.I.A.; Zreaqat, M.H.; Latip, H.F.M.; Jamaludin, M.N.; Hassan, A. Halloysite Nanotubes and Halloysite-Based Composites for Biomedical Applications. Arab. J. Chem. 2021, 14, 103294. [Google Scholar] [CrossRef]
- Yuan, P.; Tan, D.; Annabi-Bergaya, F. Properties and Applications of Halloysite Nanotubes: Recent Research Advances and Future Prospects. Appl. Clay Sci. 2015, 112–113, 75–93. [Google Scholar] [CrossRef]
- Carazo, E.; Borrego-Sánchez, A.; García-Villén, F.; Sánchez-Espejo, R.; Aguzzi, C.; Viseras, C.; Sainz-Díaz, C.I.; Cerezo, P. Assessment of Halloysite Nanotubes as Vehicles of Isoniazid. Colloids Surf. B Biointerfaces 2017, 160, 337–344. [Google Scholar] [CrossRef]
- Alkatheeri, M.S.; Palasuk, J.; Eckert, G.J.; Platt, J.A.; Bottino, M.C. Halloysite Nanotube Incorporation into Adhesive Systems—Effect on Bond Strength to Human Dentin. Clin. Oral Investig. 2015, 19, 1905–1912. [Google Scholar] [CrossRef]
- Salmerón-Valdés, E.N.; Cruz-Mondragón, A.C.; Toral-Rizo, V.H.; Jiménez-Rojas, L.V.; Correa-Prado, R.; Lara-Carrillo, E.; Morales-Valenzuela, A.A.; Scougall-Vilchis, R.J.; López-Flores, A.I.; Hoz-Rodriguez, L.; et al. Mechanical Properties and Antibacterial Effect on Mono-Strain of Streptococcus Mutans of Orthodontic Cements Reinforced with Chlorhexidine-Modified Nanotubes. Nanomaterials 2022, 12, 2891. [Google Scholar] [CrossRef]
- Takahashi, Y.; Imazato, S.; Kaneshiro, A.V.; Ebisu, S.; Frencken, J.E.; Tay, F.R. Antibacterial Effects and Physical Properties of Glass-Ionomer Cements Containing Chlorhexidine for the ART Approach. Dent. Mater. 2006, 22, 647–652. [Google Scholar] [CrossRef]
- Hoszek, A.; Ericson, D. In Vitro Fluoride Release and the Antibacterial Effect of Glass Lonomers Containing Chlorhexidine Gluconate. Oper. Dent. 2008, 33, 696–701. [Google Scholar] [CrossRef]
- Türkün, L.Ş.; Türkün, M.; Ertuǧrul, F.; Ateş, M.; Brugger, S. Long-Term Antibacterial Effects and Physical Properties of a Chlorhexidine-Containing Glass Ionomer Cement. J. Esthet. Restor. Dent. 2008, 20, 29–44. [Google Scholar] [CrossRef]
- Balouiri, M.; Sadiki, M.; Ibnsouda, S.K. Methods for in Vitro Evaluating Antimicrobial Activity: A Review. J. Pharm. Anal. 2016, 6, 71–79. [Google Scholar] [CrossRef]
- Vermeersch, G.; Leloup, G.; Delmée, M.; Vreven, J. Antibacterial Activity of Glass-Ionomer Cements, Compomers and Resin Composites: Relationship between Acidity and Material Setting Phase. J. Oral Rehabil. 2005, 32, 368–374. [Google Scholar] [CrossRef]
- Palenik, C.J.; Behnen, M.J.; Setcos, J.C.; Miller, C.H. Inhibition of Microbial Adherence and Growth by Various Glass Ionomers in Vitro. Dent. Mater. 1992, 8, 16–20. [Google Scholar] [CrossRef]
- Bowden, G.H.W. Effects of Fluoride on the Microbial Ecology of Dental Plaque. J. Dent. Res. 1990, 69, 653–659. [Google Scholar] [CrossRef] [PubMed]
- Perales Zamora, S.; Guillen Bordaz, C.; Loayza De La Cruz, R.; Alvarado Menacho, S.; Torres Ramos, G.; Guillén Astete, A.; Anticona Huaynate, C. El Flúor En La Prevención de Caries En La Dentición Temporal. Barnices Fluorados. Odontol. Sanmarquina 2014, 9, 33. [Google Scholar] [CrossRef]
- Vamsi, K.; Siddiqui, F. Antimicrobial Effect of an Experimental Glass Ionomer Cement against Pathogens Associated with Deep Carious Lesions. J. Contemp. Dent. Pract. 2018, 19, 824–829. [Google Scholar] [CrossRef] [PubMed]
- Heidarinasab, A.; Ahmad Panahi, H.; Faramarzi, M.; Farjadian, F. Synthesis of Thermosensitive Magnetic Nanocarrier for Controlled Sorafenib Delivery. Mater. Sci. Eng. C 2016, 67, 42–50. [Google Scholar] [CrossRef]
- Renné, W.G.; Lindner, A.; Mennito, A.S.; Agee, K.A.; Pashley, D.H.; Willett, D.; Sentelle, D.; Defee, M.; Schmidt, M.; Sabatini, C. Antibacterial Properties of Copper Iodide-Doped Glass Ionomer-Based Materials and Effect of Copper Iodide Nanoparticles on Collagen Degradation. Clin. Oral Investig. 2017, 21, 369–379. [Google Scholar] [CrossRef] [PubMed]
- Feitosa, S.A.; Palasuk, J.; Geraldeli, S.; Windsor, L.J.; Bottino, M.C. Physicochemical and Biological Properties of Novel Chlorhexidine-Loaded Nanotube-Modified Dentin Adhesive. J. Biomed. Mater. Res. B Appl. Biomater. 2019, 107, 868–875. [Google Scholar] [CrossRef]
- Huang, Q.; Wang, S.; Sun, Y.; Shi, C.; Yang, H.; Lu, Z. Effects of Ag/ZnO Nanocomposite at Sub-Minimum Inhibitory Concentrations on Virulence Factors of Streptococcus Mutans. Arch. Oral Biol. 2020, 111, 104640. [Google Scholar] [CrossRef]
- Feitosa, S.A.; Palasuk, J.; Kamocki, K.; Geraldeli, S.; Gregory, R.L.; Platt, J.A.; Windsor, L.J.; Bottino, M.C. Doxycycline-Encapsulated Nanotube-Modified Dentin Adhesives. J. Dent. Res. 2014, 93, 1270–1276. [Google Scholar] [CrossRef]
- Massaro, M.; Lazzara, G.; Milioto, S.; Noto, R.; Riela, S. Correction: Covalently Modified Halloysite Clay Nanotubes: Synthesis, Properties, Biological and Medical Applications. J. Mater. Chem. B 2017, 5, 4246. [Google Scholar] [CrossRef]
- Leyhausen, G.; Abtahi, M.; Karbakhsch, M.; Sapotnick, A.; Geurtsen, W. Biocompatibility of Various Light-Curing and One Conventional Glass-Ionomer Cement. Biomaterials 1998, 19, 559–564. [Google Scholar] [CrossRef] [PubMed]
- Salmerón-Valdés, E.; Scougall-Vilchis, R.; Alanis-Tavira, J.; Morales-Luckie, R. Comparative Study of Fluoride Released and Recharged from Conventional Pit and Fissure Sealants versus Surface Prereacted Glass Ionomer Technology. J. Conserv. Dent. 2016, 19, 41–45. [Google Scholar] [CrossRef]
- Kalagi, S.; Feitosa, S.A.; Münchow, E.A.; Martins, V.M.; Karczewski, A.E.; Cook, N.B.; Diefenderfer, K.; Eckert, G.J.; Geraldeli, S.; Bottino, M.C. Chlorhexidine-Modified Nanotubes and Their Effects on the Polymerization and Bonding Performance of a Dental Adhesive. Dent. Mater. 2020, 36, 687–697. [Google Scholar] [CrossRef]
- Degrazia, F.W.; Leitune, V.C.B.; Takimi, A.S.; Collares, F.M.; Sauro, S. Physicochemical and Bioactive Properties of Innovative Resin-Based Materials Containing Functional Halloysite-Nanotubes Fillers. Dent. Mater. 2016, 32, 1133–1143. [Google Scholar] [CrossRef] [PubMed]
- CLSI M100; Performance Standards for Antimicrobial Susceptibility Testing. Clinical and Laboratory Standards Institute CLSI: Berwyn, PA, USA, 2020.

| Groups | Mean (SD) |
|---|---|
| Control group: Vitrebond (VB) | 8.30 (0.483) |
| Experimental group: (VBHNT-NaF) | 9.10 (0.568) |
| Positive control group Vitrebond: (VBHNT) | 8.50 (0.527) |
| Control group: Ionobond (IB) | 0.00 (0.00) |
| Positive control group Ionobond: (IBHNT) | 0.00 (0.00) |
| Experimental group: IBHNT-NaF | 8.60 (0.516) |
| Kruskal–Wallis‘ test | p = 0.001 * |
| Groups | Statistics | Statistics Deviation | p Value |
|---|---|---|---|
| IB–VB | 25.200 | 3.402 | 0.010 * |
| IB–IBHNT | 0.000 | 0.000 | 1.000 |
| IB–VBHNT | −27.100 | −3.658 | 0.004 * |
| IB–IBHNT-NaF | −29.000 | −3.915 | 0.001 * |
| IB–VBHNT-NaF | −38.700 | −5.224 | 0.0001 * |
| IBHNT–VBHNT | −27.100 | −3.658 | 0.004 * |
| IBHNT–IBHNT-NaF | −29.000 | −3.915 | 0.001 * |
| IBHNT–VBHNT-NaF | −38.700 | −5.224 | 0.0001 * |
| VB–IBHNT | 25.200 | 3.402 | 0.010 * |
| VB–VBHNT | −1.900 | −0.256 | 1.000 |
| VB–IBHNT-NaF | −3.800 | −0.513 | 1.000 |
| VB–VBHNT-NaF | −13.500 | −1.822 | 1.000 |
| VBHNT–IBHNT-NaF | −1.900 | −0.256 | 1.000 |
| VBHNT–VBHNT-NaF | −11.600 | −1.566 | 1.000 |
| IBHNT-NaF–VBHNT-NaF | 9.700 | 1.309 | 1.000 |
Disclaimer/Publisher’s Note: The statements, opinions and data contained in all publications are solely those of the individual author(s) and contributor(s) and not of MDPI and/or the editor(s). MDPI and/or the editor(s) disclaim responsibility for any injury to people or property resulting from any ideas, methods, instructions or products referred to in the content. |
© 2025 by the authors. Licensee MDPI, Basel, Switzerland. This article is an open access article distributed under the terms and conditions of the Creative Commons Attribution (CC BY) license (https://creativecommons.org/licenses/by/4.0/).
Share and Cite
De Jesús-Pascual, R.; Salmerón-Valdés, E.N.; Morales-Valenzuela, A.A.; Jiménez-Rojas, L.V.; Correa-Prado, R.; Lara-Carrillo, E.; Toral-Rizo, V.H.; Chanes-Cuevas, O.A.; Velázquez-Enríquez, U.; Morales-Luckie, R.A.; et al. The Growth-Inhibitory Effect of Glass Ionomer Liners Reinforced with Fluoride-Modified Nanotubes. Inorganics 2025, 13, 190. https://doi.org/10.3390/inorganics13060190
De Jesús-Pascual R, Salmerón-Valdés EN, Morales-Valenzuela AA, Jiménez-Rojas LV, Correa-Prado R, Lara-Carrillo E, Toral-Rizo VH, Chanes-Cuevas OA, Velázquez-Enríquez U, Morales-Luckie RA, et al. The Growth-Inhibitory Effect of Glass Ionomer Liners Reinforced with Fluoride-Modified Nanotubes. Inorganics. 2025; 13(6):190. https://doi.org/10.3390/inorganics13060190
Chicago/Turabian StyleDe Jesús-Pascual, Ricardo, Elias Nahum Salmerón-Valdés, Adriana Alejandra Morales-Valenzuela, Leticia Verónica Jiménez-Rojas, Rodrigo Correa-Prado, Edith Lara-Carrillo, Víctor Hugo Toral-Rizo, Osmar Alejandro Chanes-Cuevas, Ulises Velázquez-Enríquez, Raúl Alberto Morales-Luckie, and et al. 2025. "The Growth-Inhibitory Effect of Glass Ionomer Liners Reinforced with Fluoride-Modified Nanotubes" Inorganics 13, no. 6: 190. https://doi.org/10.3390/inorganics13060190
APA StyleDe Jesús-Pascual, R., Salmerón-Valdés, E. N., Morales-Valenzuela, A. A., Jiménez-Rojas, L. V., Correa-Prado, R., Lara-Carrillo, E., Toral-Rizo, V. H., Chanes-Cuevas, O. A., Velázquez-Enríquez, U., Morales-Luckie, R. A., & Jaramillo-García, J. (2025). The Growth-Inhibitory Effect of Glass Ionomer Liners Reinforced with Fluoride-Modified Nanotubes. Inorganics, 13(6), 190. https://doi.org/10.3390/inorganics13060190

